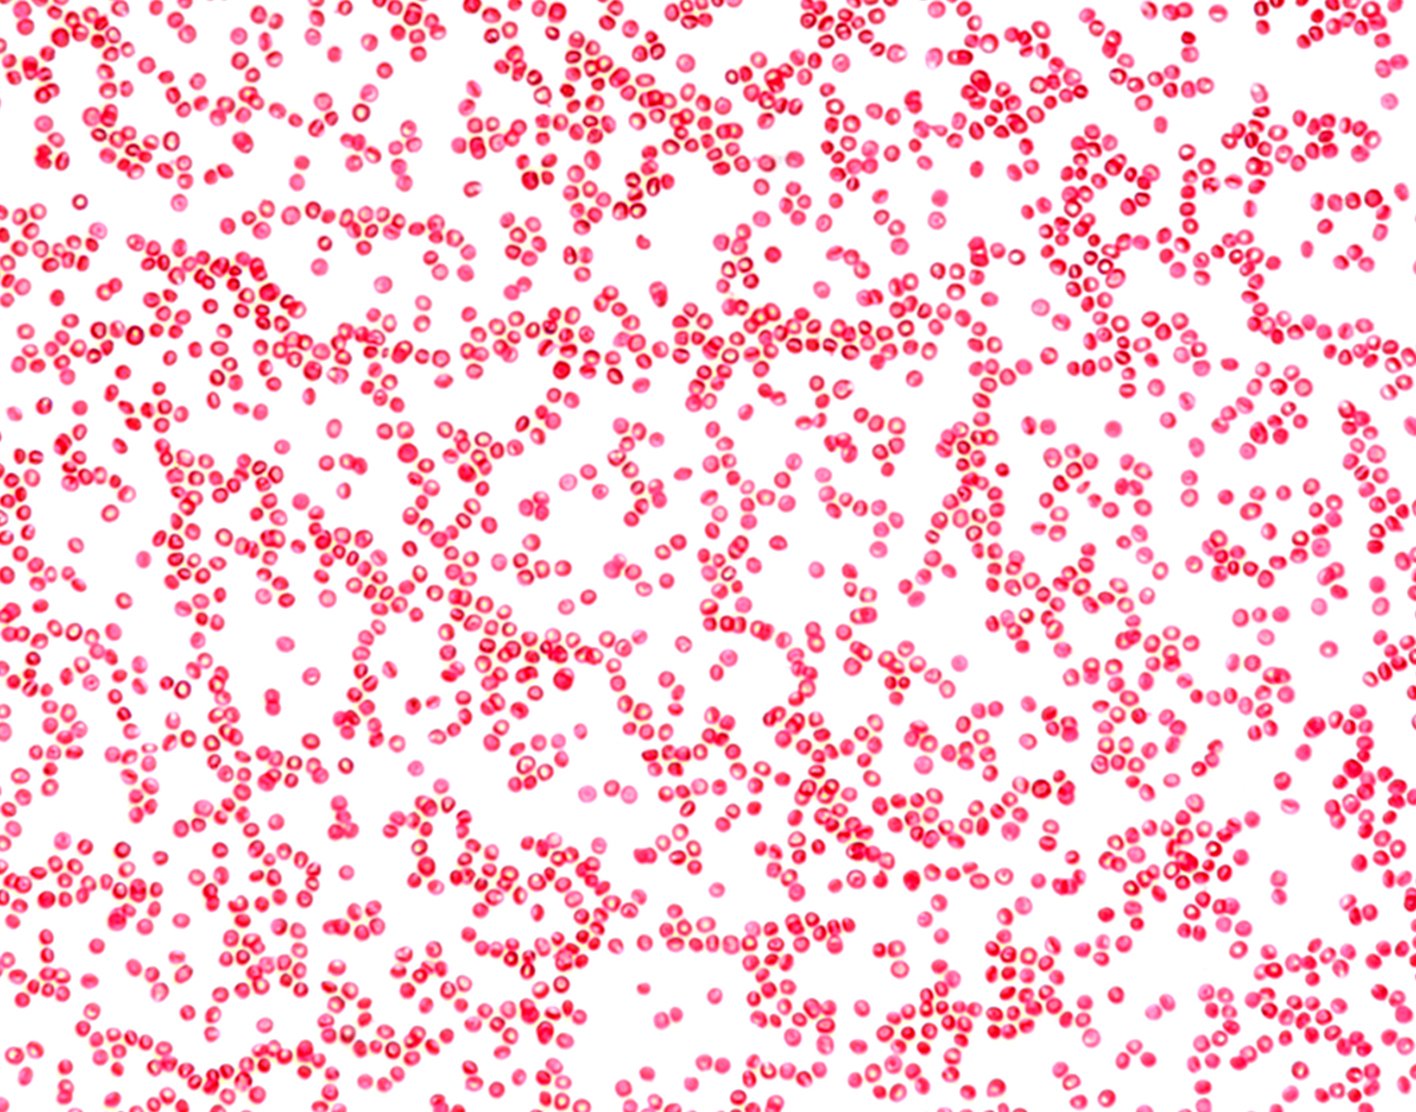

Methylene blue test
Definition
The methylene blue test is a test to determine the type or to treat
Alternative Names
Methemoglobinemia - methylene blue test
How the Test is Performed
The health care provider wraps a tight band or blood pressure cuff around your upper arm. The pressure causes veins below the area to fill with blood.
The arm is cleaned with a germ killer (antiseptic). A needle is placed into your vein, usually near the inside of the elbow or back of the hand. A thin tube, called a catheter, is placed into the vein. (This may be called an IV, which means intravenous). While the tube stays in place, the needle and tourniquet are removed.
A dark green powder called methylene blue goes through the tube into your vein. The provider looks at how the powder turns a substance in the blood called
How to Prepare for the Test
No special preparation is required for this test.
How the Test will Feel
When the needle is inserted to draw blood, some people feel moderate pain. Others feel only a prick or stinging. Afterward, there may be some throbbing or slight bruising. This soon goes away.
Why the Test is Performed
There are several types of oxygen-carrying proteins in the blood. One of them is methemoglobin. Normal methemoglobin levels in blood are usually 1%. If the level is higher, you can become sick because the protein is not carrying oxygen. This can make your blood look brown instead of red.
Methemoglobinemia has several causes, many of which are genetic (problem with your genes). This test is used to tell the difference between methemoglobinemia caused by the lack of a protein called
Normal Results
Normally, methylene blue quickly lowers the level of methemoglobin in the blood.
Normal value ranges may vary slightly among different laboratories. Some labs use different measurements or test different samples. Talk to your provider about the meaning of your specific test results.
What Abnormal Results Mean
You may have a rare form of methemoglobinemia if this test does not significantly lower the blood level of methemoglobin.
Risks
There is little risk involved with having your blood taken. Veins and arteries vary in size from one person to another and from one side of the body to the other. Inserting an IV may be more difficult for you or your child than for other people.
Other risks associated with this type of blood test are minor, but may include:
- Excessive bleeding
- Fainting or feeling lightheaded
- Multiple punctures to locate veins
- Hematoma (blood accumulating under the skin causing bruising)
- Infection (a slight risk any time the skin is broken, but the chances of infection increase the longer the IV remains in the vein)
References
Chernecky CC, Berger BJ. Methemoglobin - blood. In: Chernecky CC, Berger BJ, eds. Laboratory Tests and Diagnostic Procedures. 6th ed. St Louis, MO: Elsevier Saunders; 2013:781-782.
Neerja V, Graham S, Bem S. Basic examination of blood and bone marrow. In: McPherson RA, Pincus MR, eds. Henry's Clinical Diagnosis and Management by Laboratory Methods. 24th ed. Philadelphia, PA: Elsevier; 2022:chap 31.
Review Date: 13/10/2022
The information provided herein should not be used during any medical emergency or for the diagnosis or treatment of any medical condition. A licensed physician should be consulted for diagnosis and treatment of any and all medical conditions. Call 911 for all medical emergencies. Links to other sites are provided for information only -- they do not constitute endorsements of those other sites. Copyright ©2019 A.D.A.M., Inc., as modified by University of California San Francisco. Any duplication or distribution of the information contained herein is strictly prohibited.
Information developed by A.D.A.M., Inc. regarding tests and test results may not directly correspond with information provided by UCSF Health. Please discuss with your doctor any questions or concerns you may have.